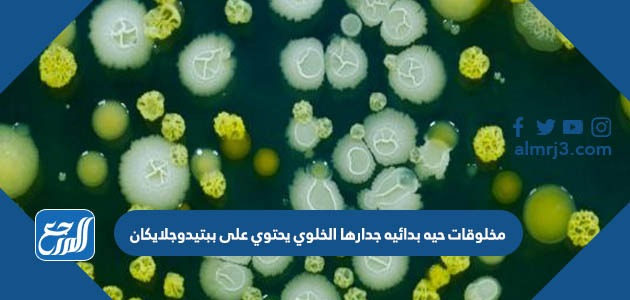
مخلوقات حيه بدائيه جدارها الخلوي يحتوي على ببتيدوجلايكان

مخلوقات حيه بدائيه جدارها الخلوي يحتوي على ببتيدوجلايكان
جدول المحتويات
مخلوقات حيه بدائيه جدارها الخلوي يحتوي على ببتيدوجلايكان، تتعدد وتختلف الكائنات الحية التي تعيش على كوكب الأرض فمنها المخلوقات الحية البدائية أو المملكة الحيوانية، لذا أهتم العلماء بتصنيف الكائنات الحية وفقًا لأنواعها وأشكالها والأدوار التي تقوم بها، وفيما يلي عبر موقع المرجع سوف نلقي الضوء على المخلوقات الحية التي يحتوي جدارها الخلوي على ببتيدوجلايكان.
مخلوقات حيه بدائيه جدارها الخلوي يحتوي على ببتيدوجلايكان
يُعرف الجدار الخلوي في اللغة الإنجليزية بـ Cell Wall، وهو عبارة عن غلاف يوجد خارج الكائنات الحية الحيوانية، ويحيط بالغشاء البلازمي لها، ومن أبرز ما يميزه صلابته، علاوة على أهميته في حماية الخلية، وفي إطار ذلك يمكن القول أن:
- مخلوقات حيه بدائيه جدارها الخلوي يحتوي على ببتيدوجلايكان هي البكتيريا الحقيقية.
ماهي البكتيريا الحقيقية
هي عبارة عن مخلوقات حية وحيدة الخلية مجهرية، يمكنها العيش في مجموعات كبيرة في البيئة المائية بمختلف أنواعها وأشكالها وأحجامها بداية من الفتحات العميقة التي توجد في البحار إلى أعمق ما يوجد في الأرض، ويمكن للبكتيريا الحقيقة النمو سريعًا حيث تحاط النواة المحاطة بها بالغشاء لذلك تعتبر من أشهر أنواع البكتيريا انتشارًا.[1]
شاهد أيضًا: التكاثر الجنسي هو انتاج مخلوقات حية جديدة من أب واحد
تركيب البكتيريا الحقيقية
فيما يلي سوف نلقي الضوء على التركيب العام للبكتريا الحقيقة كما يلي:[1]
- الجدار الخلوي: يُعرف في اللغة الإنجليزية بـ Cell wall، وهو عبارة عن غلاف رئيسي لا غنى عنه في الكائنات الحية، كما يتكون هذا الجدار من مجموعة من البروتينات السكرية، ويساعد على حماية وحدة الخلية من الانفجار عندما توجد في الأوساط الأقل في نسبة التركيز.
- الكبسولة: تُعرف في اللغة الإنجليزية بـ Capsules، تشبه المواد التي تتكون منها الكبسولة مادة هلامية لزجة سميكة، وظيفتها الأساسية حماية البكتيريا من المواد الكيميائية الضارة، علاوة على قدرتها على مدها بالغذاء اللازم لضمان بقائها وتكاثرها.
- الأوسط: تُعرف في اللغة الإنجليزية بـ (Flagella)، وهو عبارة عن ذيل مستدير قوي وصلب وظيفته الأساسية التحرك سريعًا مع قارب الساعة، كما يعتبر هذا المسؤول عن حركة الخلية.
- الغشاء البلازمي: يعرف في اللغة الإنجليزية بـ Plasma Membrane، ويسمى غشاء البلازما أيضًا بـ (الخلية السيتوبلازمي)، وهو عبارة عن عشاء يساهم في نقل المواد والعناصر الغذائية داخل وخارج الخلية.
- السيتوبلازم: تعرف في اللغة الإنجليزية بـ Cytoplasm، وهو عبارة عن مخزن يمكن من خلالها نقل المواد الكيميائية التي تلعب دورًا هامًا في حماية الخلايا والحفاظ عليها.
- الريبسوم: يعرف في اللغة الإنجليزية بـ Ribosome، وهو عبارة عن حبيبات صغيرة جدًا تتكون من الحمض النووي الريبوزي والبروتينات.
شاهد أيضًا: هو كل ما يحيط بنا من نجوم ومجرات ومخلوقات حية
وبذلك نكون قد وصلنا إلى نهاية مقالنا بعد أن تعرفنا من خلاله على إجابة سؤال مخلوقات حيه بدائيه جدارها الخلوي يحتوي على ببتيدوجلايكان، كما تعرفنا أيضًا على تعريف البكتيريا الحقيقية وتركيبها.
المراجع
- livescience.com , What Are Bacteria? , 27/09/2021








